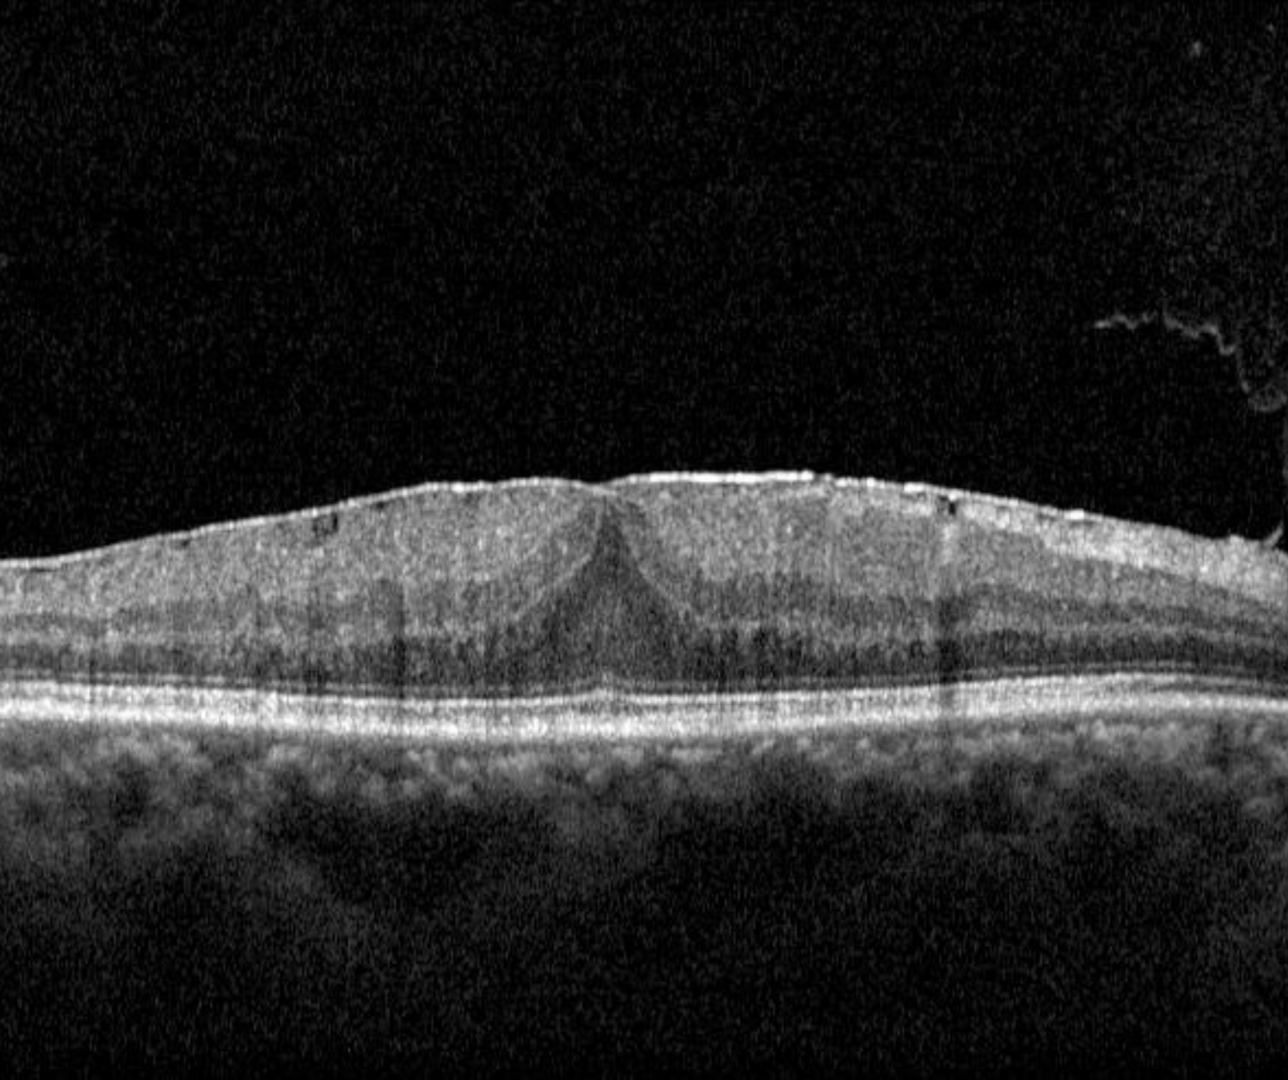

Overview
An epiretinal membrane (ERM) is a membrane of glial cells and laminocytes attached to remnants of the vitreous cortex on the retinal surface. Clinically, it appears as wrinkling of the retinal surface with an abnormal sheen or reflectivity.
On OCT, it can be seen as a thin hyper-reflective layer above the internal limiting membrane (ILM). It can cause tractional stress on the underlying retina and may be associated with wrinkling of the retinal surface, loss of the foveal pit, retinal thickening and cystic spaces. In advanced cases, there can also be disruption of the inner segment elllipsoid zone and photoreceptor outer segments which can cause further reduction in visual acuity.
ERM's are mostly commonly idiopathic (likely resulting from anomalous posterior vitreous detachment), but can also occur as a result of trauma, inflammation, intraocular surgery, tumours, vascular disease and retinal tears or detachments.
Case Examples
-
Case 1: ERM
A 63 year old Asian male with best corrected visual acuity of 6/9.5+ (20/32+) in the right eye. Testing with an Amsler grid revealed no distortion of the vision in the right eye.
-
Case 2: ERM with associated retinal thickening
A 59 year old Asian female with best corrected visual acuity of 6/7.5+ (20/25+) in the right eye. Testing with an Amsler grid showed mild generalised waviness of the grid.
-
Case 3: ERM with intra-retinal cystic spaces
A 70 year old Caucasian male with best corrected visual acuity of 6/12 (20/40) in the right eye. Central distortion was noted on testing with an Amsler grid.
-
Case 4: ERM with ectopic inner foveal layers
A 64 year old Asian female with best corrected visual acuity of 6/7.5 (20/25) in the left eye. Testing with an Amsler grid revealed distortion of the vertical lines while the horizontal lines appeared unaffected.
Differential Diagnosis
References
Govetto A, Lalane RA, Sarraf D, Figueroa MS, Hubschman JP. (2017) Insights Into Epiretinal Membranes: Presence of Ectopic Inner Foveal Layers and a New Optical Coherence Tomography Staging Scheme. Am J Ophthalmol. 175:99-113.
Stalmans, P. Duker, J. Kaiser, PK. Heier, JS. Dugel, P et al. (2013) OCT-Based interpretation of the vitreomacular interface and indications for pharmacologic vitreolysis. Retina Volume 33 - Issue 10